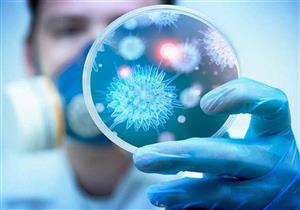
"فيروس من صُنع اليهود"..  كيف استغل "داعش" و"النازيين الجدد" جائحة كورونا لخلق الفوضى؟

إعلان
-
06 يناير, 2025
-
28 ديسمبر, 2023
-
15 أغسطس, 2023
-
29 يونيو, 2023
-
27 أكتوبر, 2022
-
20 أبريل, 2022
-
10 يناير, 2022
-
15 أغسطس, 2021
-
29 أبريل, 2021
-
26 أبريل, 2021
-
18 يناير, 2021
-
07 أبريل, 2020
-
إعلان
-
27 أبريل, 2019
-
12 مارس, 2019
-
17 ديسمبر, 2018
-
07 مارس, 2018
-
04 مارس, 2018
-
23 فبراير, 2018
-
11 فبراير, 2018
-
07 فبراير, 2018
-
12 يناير, 2018
-
15 سبتمبر, 2017
-
16 يوليو, 2017
-
07 يونيو, 2017
إعلان
الجابون
موزمبيق
الجزائر
بوركينا فاسو
غينيا الاستوائية
السودان
كوت ديفوار
الكاميرون
-

عرض صيني ضخم يهدد مستقبل ديانج مع الأهلي.. ما القصة؟
-

"محتاجين يتعالجوا".. حمادة عبداللطيف ينتقد الهجوم على المنتخب في كأس الأمم
-

"تفوق الفراعنة ومتعب الهداف".. تاريخ مواجهات منتخب مصر وأنجولا
-

15 صورة لإصابة محمد علي بن رمضان القوية مع منتخب تونس أمام نيجيريا
-

التاروت يتوقع مشوار منتخب مصر في أمم أفريقيا
أخبار منتخبات كأس الأمم الأفريقية

إعلان